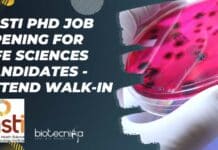
THSTI PhD Job Opening For Life Sciences Candidates – Attend Walk-In THSTI PhD Job Opening

SGPGIMS Biotech, Biochem, Human Genetics JRF/ Project Associate Recruitment
SGPGIMS Biotech, Biochem, Human Genetics JRF/ Project Associate Recruitment
SGPGIMS Biotech, Biochem, Human Genetics JRF/ Project Associate Recruitment. SGPGIMS is recruiting candidates for a research...
IISc MSc NON-NET Biology Project Associate Recruitment, Apply Online
IISc MSc Biology Project Associate Recruitment For NON-NET Candidates, Apply Online
IISc MSc Biology Project Associate Recruitment For NON-NET Candidates, Apply Online. MSc biology jobs....
Biotecnika Times Newsletter 22.11.2022 NABI Training, NDDB Trainee, Syngene BSc
Biotecnika Times Newsletter 22.11.2022 NABI Training, NDDB Trainee, Syngene BSc
NABI Research Training With Project Opportunity For 4-6 Months In 2023
NABI, Mohali has announced the...
SGPGIMS Research Assistant Job For MSc & BTech Candidates, Applications Invited
SGPGIMS Research Assistant Vacancy For MSc & BTech Candidates
SGPGIMS Research Assistant Vacancy For MSc & BTech Candidates. SGPGIMS is recruiting candidates for a research...
Biological Sciences Institute Post-Doctoral Fellow Opening at IISER Bhopal
PhD Biological Sciences Job at IISER Bhopal, Applications Invited
PhD Biological Sciences Job at IISER Bhopal, Applications Invited. IISER Bhopal Vacancy for PhD Biological Sciences....
NABI Research Training With Project Opportunity For 4-6 Months In 2023
NABI Research Training 2023 With Project Opportunity For 4-6 Months
NABI, Mohali has announced the notification for an Opportunity for 4 to 6 months (NABI...
Syngene BSc Biotech, Biochem Job Opening, Apply Online
Syngene BSc Biotech, Biochem Job Opening, Apply Online
Syngene BSc Biotech, Biochem Job Opening, Apply Online. BSc Biotechnology and Biochemistry Job in Syngene, Bangalore. Syngene...
TCS Hiring Life Sciences For Medical Writer Vacancy, Apply Online
TCS Medical Writer Vacancy For Life Sciences, Apply Online
TCS Medical Writer Vacancy For Life Sciences, Apply Online. Graduate and Postgraduate life sciences candidates apply...
Calcutta University Dept of Biochem JRF Job For Biotech, Biochem, Biophysics
Calcutta University JRF Opening For Biotech, Biochem, Biophysics
Calcutta University JRF Opening For Biotech, Biochem, Biophysics. JRF Job opening at Calcutta University. Interested and eligible...
THSTI PhD Job Opening For Life Sciences Candidates – Attend Walk-In
THSTI PhD Job Opening For Life Sciences Candidates - Attend Walk-In
THSTI PhD Job Opening For Life Sciences Candidates - Attend Walk-In. Life Sciences, job....
NIPGR PhD Plant Molecular Biology, Life Sciences, Biotech Research Job
NIPGR PhD Vacancy 2022 For Biotech, Life Sciences, Plant Mol Bio
NIPGR PhD Vacancy 2022 For Biotech, Life Sciences, Plant Mol Bio. PhD Biotechnology/ Life...
ACTREC BTech, MTech & MSc Biotech, Life Sciences Scientific Assistant Recruitment
ACTREC Scientific Assistant Opening For BTech, MSc & MTech Candidates
ACTREC Scientific Assistant Opening For BTech, MSc & MTech Candidates. MSc, BTech and MTech Biotechnology,...
Biotecnika Times Newsletter 21.11.2022 CDRI Jobs, NCCS Admission, Summer Academies Fellowship
Biotecnika Times Newsletter 21.11.2022 CDRI Jobs, NCCS Admission, Summer Academies Fellowship
CSIR-CDRI BTech, MSc Biotech, Life Sciences Project Jobs - Attend Walk-In
CSIR-CDRI Project Jobs 2022...
Alagappa University Project Fellows Recruitment – Applications Invited
Alagappa University Project Fellows Recruitment - Applications Invited
Alagappa University Project Fellows Recruitment - Applications Invited. Interested and eligible applicants can check out all of...
Danaher Biotech, Biochem, Microbiology Scientist Job Opening, Apply Online
Danaher Biotech, Biochem, Microbiology Scientist Job Opening, Apply Online
Danaher Biotech, Biochem, Microbiology Scientist Job Opening, Apply Online. Danaher Life Sciences companies jobs. Bengaluru scientist...